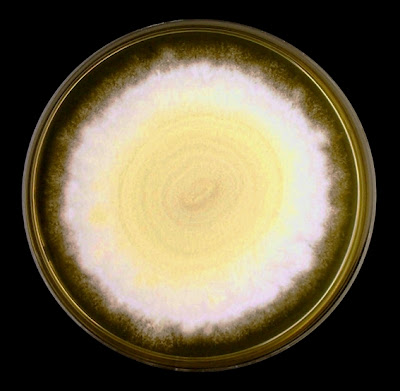

Trichophyton mentagrophytes Complex(Fungus, Dermatophyte)
Ecology: T.mentagrophytes is recognized as having two variants. Anthropophilic isolates prefer man to animals while the zoophilic isolates primarily infect animals. Small rodents appear to be the primary reservoir for the animal variety. Trichophyton mentagrophytes is a cosmopolitan fungus (found everywhere).
Macroscopic Morphology: T.mentagrophytes exhibits moderately rapid growth and matures within 6 – 10 days. Sources have previously described anthropophilic isolates having a downy, powdery or even fluffy texture while zoophilic isolated were more granular in appearance. Colonies may vary in colour from white to cream or yellowish. The reverse also can vary from yellow to reddish brown to brown or ochre, depending on isolate and medium.
Trichophyton mentagrophytes -5 days growth on SAB at 30oC
Trichophyton mentagrophytes - 14 days growth on SAB at 30oC
Microscopic Morphology: Trichophyton mentagrophytes produces septate hyphae from which branched conidiophores extend. Sessile (not on stalk) microconidia are produced in rather dense, grape-like clusters on the conidiophores. The microconidia (~2µm to 4µm) are spherical to pyriform in shape. Macroconidia (20-50µm to 6-8µm) are cigar to club shaped and may show exhibit some distortion. Macroconidia have a smooth exterior and are thin walled, usually have between 3 to 8 cells dividing the interior. Macroconidia may be found more readily in younger cultures. Production of both micro & macro conidia may vary with the isolate. Coiled or spiral hyphae may be present and in some strains, structures described as nodular bodies or chlamydospores may be present.
Note: All photos which follow were taken with the DMD-108 digital microscope.
T.mentagrophytes showing sessile microconidia along septate hyphae.
Note 100µm bar in upper right of this and several other photos.
(400x, LPCB)
Trichophyton mentagrophytes - branched conidiophores bearing spherical conidia in clusters seen extending from septate hyphae. (400x, LPCB)
T.mentagrophytes - another view as above. A macroconidium can be seen near the lower center of the photo (400x, LPCB)
T.metagrophytes - a closer look at the branched condiophores bearing clusters of spherical microconidia. Septations are visible in the hyphae and conidiophores.
(1000x, LPCB)
T.mentagrophytes -another look as in the previous photo.
(1000x, LPCB)
T.mentagrophytes - A 7-celled macroconidium. Macroconidia are typically described as being cigar shaped or club shaped.
(400x, LPCB)
T.mentagrophytes - another 7-celled macroconidium with dimensions (inset)
(400+10x, LPCB)
T.mentagrophytes -an macroconidium which shows slight distortion (sides are not straight). Numerous spherical microconidia in lower right.
(1000x, LPCB)
T.mentagrophytes - a solitary cigar shaped macroconidium showing seven internal cells. Walls are rather thin and the exterior is smooth.
(1000+10x, LPCB)
T.mentagrophytes - just by chance all this, and the previous macroconida all contain seven cells. I found that young cultures (~3 days) produced the most macroconidia which seemed to diminish with additional incubation. That said, the macroconidium pictured here is from a 6 day old slide culture. It should always be kept in mind that structures may appear, disappear, develop or change with length of incubation. It may be advisable to make several side cultures and harvest them at different time periods to observe development of structures.
(1000+10x, LPCB)
T.mentagrophytes - a couple of macroconidia are seen in this photo as well as clusters of microconidia. A spiral hyphal element is seen in the upper center of the photo.
(400+10x, LPCB)
T.mentagrophytes - a spiral hyphae is seen seen in the center left of this photo as it overlaps a macroconidium. Microconidia throughout the photo.
(1000x, LPCB)
T.mentagrophytes - more examples of spiral hyphae typical to T.mentagrophytes seen in this photo.
(400+10x, LPCB, 8 days incubation)
T.mentagrophytes - one last photo showing what is described as a nodular body or chlamydospore. Clusters of microconidia seen in center-left.
(1000+10x, LPCB, 10 days incubation)
Physiological Tests: a number of classical tests can be employed to speciate Trichophytonspecies.
· Urease test: Positive
· BCP-Milk Solids Glucose: Alkaline reaction
· Hair perforation test: Positive
· Growth at 37oC: Excellent
· Growth factor requirement*: None
*a variety of Trichophytontubed agars are commercially available containing specific growth supplements (eg.inositol, thiamine, nicotinic acid, histidine). The pattern or degree of growth in each can assist the speciation of Trichophyton.
Pathogenicity: The anthropophilic strains are usually associated with chronic infections of glabrous skin, scalp, beard, nails and feet.
It is currently recommended* that Trichophyton mentagrophytes be reported as ‘Trichophyton mentagrophytes complex’ which also includes the former Trichophyton krajdenii.
*Best Practice by QMP-LS, external quality assessment agency.
* * *
.jpg)
.jpg)
.jpg)













